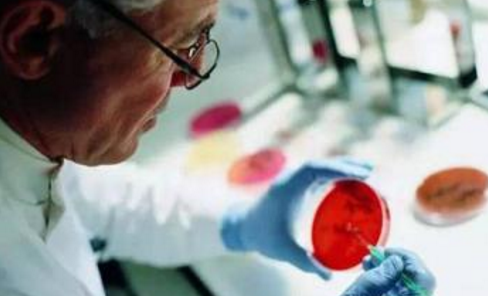

- 海外医疗服务平台,出国就医领导品牌

吉三代|Epclusa
咨询问价:400-1033-120
 扫一扫微信咨询
扫一扫微信咨询
注:本网站任何关于药品使用的建议仅供参考,不能替代医嘱
- 同类推荐
更多 >>药品问答
-

吉三代服用中文说明书...
2018-08-01 -

为什么丙肝患者要选择吉三代?正规的购买流程是怎样的?...
2018-06-28 -

丙肝患者服用吉三代注意事项...
2018-09-20 -

吉三代治愈率有多少,价格多少钱?...
2018-08-01 -

2天售4.3亿,被患者评为最好用的丙肝神药吉三代...
2018-06-28 -

吉三代有哪些优势?...
2018-06-28 -

在大连工作的张先生通过福生国际医疗成功治愈丙肝!现已出国工作!...
2018-07-23 -

丙通沙(吉三代)服用后胃痛,可以用胃药缓解吗?...
2018-09-03 -

印度吉三代价格多少钱,直邮到中国需要多长时间?...
2018-08-06 -

胃病患者用索非布韦、吉二代、吉三代治疗丙肝注意什么...
2018-09-03
 400-1033-120
400-1033-120






 海外药房
海外药房

拨打电话
拨打电话